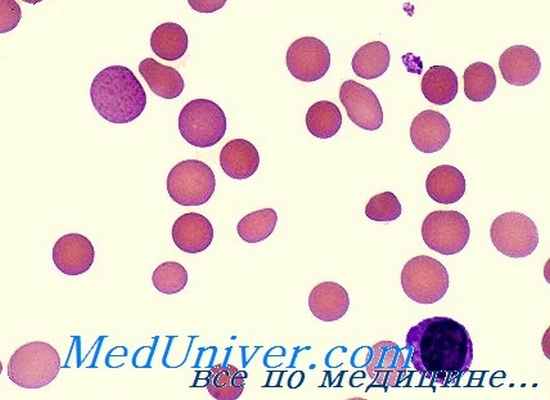
гемолитические анемии

Классификация гемолитических анемий - этиологическая, патогенетическая
Добавил пользователь Валентин П. Обновлено: 07.01.2026
Анемия - клинико-гематологический синдром, характеризующийся снижением содержания гемоглобина в единице объема крови. В соответствии с рекомендациями всемирной организации здравоохранения (ВОЗ), анемия диагностируется при снижении гемоглобина ниже 110 г/л у детей в возрасте до 5 лет, ниже 115 г/л -в возрасте от 5 до 12 лет, ниже 120 г/л у детей старше 12 лет [1]. Анемия может быть проявлением многих патологических состояний, как связанных с первичным поражением системы крови,так и не зависящих от него.
Успех лечебных мероприятий и качество жизни ребенка с анемией во многом зависят от раннего установления ее причины. Сталкиваясь с проблемой анемии, каждый педиатр должен понимать, что проводимая терапия не сводится к восстановлению нормального уровня гемоглобина крови, она должна основываться на понимании патогенетических механизмов гематологических нарушений у пациента. В настоящее время существует несколько различных классификаций анемии, разработанных с целью выделения основных механизмов ее развития и систематизации проводимых диагностических мероприятий. В связи с тем, что причиной снижения гемоглобина крови может оказаться практически любое заболевание, строгая этиологическая классификация анемий невозможна. Однако общность патогенетических механизмов развития малокровия позволяет объединить ряд анемических состояний самой разнообразной этиологии в несколько групп.
Основные механизмы развития анемий были выделены еще в 1930-е годы профессором М.П. Конча-ловским: кровопотеря, усиленное кроверазрушение и нарушение кровообразования [2]. Данный патогенетический принцип лежит и в основе современной классификации анемических состояний, предложенной как отечественными, так и зарубежными авторами (табл. 1) 5.
Таблица 1. Этиопатогенетическая классификация анемий
Постгеморрагические анемии
Острая постгеморрагическая
Анемии вследствие нарушения образования эритроцитов
Анемии вследствие дефицита белка, микроэлементов (железа, меди), витаминов (С, В6, В12, фолиевой кислоты)
Дизэритропоэтические анемии вследствие подавления эритропоэза, снижения утилизации железа (на фоне инфекционных, онкологических заболеваний, патологии печени, почек, системных заболеваний соединительной ткани)
Анемии вследствие патологии костного мозга (гипо- и апластические анемии, анемии на фоне гематоонкологических заболеваний)
Внутриклеточный гемолиз (патология мембран эритроцитов, патология ферментов эритроцитов, дефекты гемоглобина)
Внеклеточный гемолиз (иммунная и неиммунная гемолитические анемии)
Данная классификация действительно важна для определения тактики ведения пациентов, однако в практической работе дифференциальный диагноз анемии обычно начинается с анализа гемограммы. Большинство современных анализаторов в настоящее время позволяют врачу получить данные не только об уровне гемоглобина и количестве эритроцитов, но и оценить дополнительные параметры, характеризующие состояние «красной крови» (табл. 2). В зависимости от цветового показателя, который обычно коррелирует с уровнем MCH, анемии могут быть разделены на гипо-, нормо- и гиперхромные (табл. 3). Средний объем эритроцитов свидетельствует о размерах красных клеток и позволяет разделить анемии на микро-, нормо- и макроци-тарные (табл. 4) [3]. Еще одним информативным показателем для дифференциальной диагностики анемических состояний является уровень ретикуло-цитов. В норме в периферической крови содержится 0,5-1% предшественников эритроцитов. Для аре-генераторных состояний (апла-стическая анемия) характерно полное отсутствие ретикулоцитов в мазке крови. При гипорегенера-торных анемиях (железодефицит-ная, В12-дефицитная, сидеробласт-ная анемии) доля ретикулоцитов обычно составляет менее 0,5%, хотя может оставаться и в пределах нормы. Норморегенератор-ный характер анемии (ретикуло-циты 0,5-2%) свидетельствует о нормальной способности костного мозга к усилению эритро-поэза, что характерно для острых постгеморрагических анемий. К гиперрегенераторным анемиям относятся практически все гемолитические анемии, при которых количество ретикулоцитов в периферической крови обычно превышает 2-5%. Еще более точным показателем эритропоэза является ретикулоцитарный индекс (РИ), который вычисляется по формуле: РИ = [число ретикулоцитов (%) х гематокрит больного (%) / гемато-крит в норме (%)]. В норме ретикулоцитарный индекс равен 1. При острой постгеморрагической анемии данный показатель повышается обычно в 2-3 раза, а при гемолизе - в 5-6 раз выше нормы.
Таблица 2. Параметры, характеризующие состояние эритроцитов
Показатель
Физиологическое значение
Нормальный уровень
Цветовой показатель (ЦП)*
Характеризует степень насыщения эритроцита гемоглобином
Среднее содержание гемоглобина в эритроците (MCH, Mean Corpuscular Hemoglobin)
Характеризует содержание гемоглобина в эритроците
27-31 пикограмм (pg)
Средняя концентрация гемоглобина в эритроците (МСНС, Mean Corpuscular Hemoglobin Concentration)
Характеризует степень насыщения эритроцита гемоглобином
Средний объем эритроцитов (MCV, Mean Corpuscular Volume)
Характеризует объем эритроцитов
72-79 мкм3 (фентолитров, fL)
Показатель анизоцитоза (RDW, Red cell Distribution Width)
Дает количественную оценку разброса эритроцитов по объему
Таблица 3. Классификация анемий в зависимости от уровня MCH и цветового показателя
Показатели
Анемии
Гипохромная анемия ЦП < 0,85; MCH < 27pg
Железодефицитная анемия Талассемии
Нормохромная анемия ЦП 0,85-1,05 MCH 27-31 pg
Острая постгеморрагическая анемия Гемолитические анемии Апластическая анемия
Анемия при неопластических заболеваниях костного мозга Анемия вследствие снижения выработки эритропоэтина
Гиперхромная анемия ЦП > 1,05 MCH > 31 pg
Витамин В12-дефицитная анемия Фолиеводефицитная анемия
Таблица 4. Классификация анемий в зависимости от объема эритроцитов
Показатели
Анемии
Микроцитарная (гипохромная) анемия
Железодефицитная анемия Талассемии
Сидеробластная анемия
Анемия при хронических инфекционных заболеваниях Анемия при выраженных нарушениях питания
Острая постгеморрагическая анемия Анемия при патологии печени и почек
Анемия при системных заболеваниях соединительной ткани Апластическая анемия
Анемия при диссеминированных злокачественных образованиях Дизэритропоэтическая анемия Ранние стадии дефицита железа
Витамин В12-дефицитная анемия Фолиеводефицитная анемия Апластическая анемия Гипотиреоз
Состояние после спленэктомии
Таким образом, определив характер анемии при первичном анализе гемограммы пациента, можно с довольно с высокой вероятностью определить возможную причину снижения гемоглобина и четко спланировать дальнейшие диагностические мероприятия с целью установления этиологии анемического состояния.
Приводим несколько собственных наблюдений.
Клинический пример № 1
Мальчик Ф., 2 года 9 месяцев, находился в грудном инфекционном отделении Тушинской ДГБ с диагнозом: Острая респираторная вирусная инфекция, острый левосторонний средний катаральный отит. Из анамнеза известно, что ребенок от первой беременности у женщины 27 лет, протекавшей с инфекцией мочевыводящих путей в третьем триместре, в связи с чем пациентка получала Канефрон. Роды срочные, физиологические. Вес ребенка при рождении 3890 г, длина тела - 56 см. Оценка по шкале Апгар 8/8 баллов. На грудном вскармливании до 1 года 9 месяцев. Прикорм введен с 4 месяцев (овощное пюре домашнего приготовления, каши инстантные). Острыми респираторными заболеваниями до 2 лет ребенок болел 3-4 раза в год в легкой форме. За 2 месяца до госпитализации пациент отдыхал с родителями в Турции. После возвращения в Москву у ребенка отмечалось 4 эпизода острой респираторной инфекции, рецидивирующее течение отита. Очер едной эпизод повышения температуры стал поводом для госпитализации в стационар. Данные осмотра ребенка при поступлении в отделение: состояние средней тяжести, температура тела 38 °С. Отмечаются симптомы интоксикации в виде вялости, быстрой утомляемости, снижения аппетита. Кожные покровы и видимые слизистые бледные, чистые от сыпи. Периферические лимфоузлы пальпируются в основных группах, мелкие, подвижные, безболезненные. Дыхание в легких везикулярное, проводится сим-ме трично во все отделы. Тоны сердца удовлетворительной звучности, ритмичные, нежный систолический шум на верхушке сердца. Печень пальпируется по краю реберной дуги. Физиологические отправления в норме. Показатели гемограммы: Hb 71г/л, эритроциты - 2,43 х 10 12, ЦП 0,88, МСУ 75 fL, MCH 30 pg, RDW 14%, ретикулоциты - 0,4%, тромбоциты 135 тыс, лейкоциты - 2,1 тыс, п/я -6%, с/я - 9%, лимфоциты - 81%, эозинофилы - 1%, моноциты - 3%, СОЭ - 35 мм/ч.
Результаты клинического анализа крови позволили диагностировать наличие у ребенка нормохромной нормоцитарной гипорегенера-торной анемии средней степени тяжести, сопровождающейся лейкопенией, нейтропенией, тромбоцитопенией, что указывает на вероятное вовлечение в патологический процесс костного мозга. Данная гемограмма с учетом возраста ребенка, указаний на предшествовавшую заболеванию повышенную инсоляцию, рецидивирующее течение инфекционных заболеваний требует обязательного исключения гемато-онкологического заболевания (дебюта острого лейкоза). В отделении ребенку были проведены дополнительные исследования:
■ в биохимическом анализе крови железо сыворотки, ферритин, общая железосвязывающая способность сыворотки крови и содержание фолиевой кислоты находились в пределах возрастной нормы;
■ при ультразвуковом исследовании брюшной полости выявлена умеренная гепатоспленомегалия, увеличение лимфоузлов в воротах печени до 6 мм в диаметре;
■ результаты обследования на ВИЧ, гепатиты В и С, цитомегаловирус,герпес 1, 2 типа, вирус Эпштейна-Барр - отрицательные.
■ Была проведена стернальная пункция, на основании анализа результатов которой у ребенка был диагностирован острый лимфобластный лейкоз, а выявленная анемия была проявлением основного заболевания.
Клинический пример № 2
Показатели гемограммы в первые сутки госпитализации: Hb 100 г/л, эритроциты - 3,0 х 10 12 , ЦП 1,0, МО/ 72 fL, MCH 29 pg, RDW 13,5%, ретикулоциты - 2%, тромбоциты 209 тыс, лейкоциты - 11,5 тыс, с/я - 65%, лимфоциты - 26%, моноциты 9%, СОЭ 51 мм/ч. На вторые сутки госпитализации у ребенка отмечалось ухудшение состояния в виде нарастания вялости, усиления бледности и появления желтушности кожных покровов. Моча приобрела темную окраску.
В контрольном анализе крови: Hb 65 г/л, эритроциты - 2,3 х 10 12 , ЦП 0,85, МС/ 75 fL, MCH 30 pg, ре-тикулоциты - 2,5%, тромбоциты -230 тыс, лейкоциты - 15,7 тыс, с/я - 65%, лимфоциты - 28%, моноциты - 7%.
На основании анализа клинического исследования крови у ребенка была диагностирована нормохромная нормоцитарная гиперрегенераторная анемия тяжелой степени, что, в сочетании с клиническими данными (появление иктеричности кожных покровов, потемнение мочи) позволило установить ее гемолитический характер.
По результатам дополнительно проведенных исследований было выявлено:
■ в биохимическом анализе крови: повышение уровня аспа-ратаминотрансферазы (АСТ) 114 ел/л, общего билирубина 80 мкмоль/л, прямого билирубина 16 мкмоль/л, лактатдегидрогена-зы (ЛДГ) 3049 ед/л;
■ на рентгенограмме органов грудной клетки выявлена легкая инфильтрация в нижних отделах справа без четких контуров, усиление легочного рисунка;
■ серологическое обследование на инфекции выявило наличие в диагностическом титре антител класса IgM к Mycoplasma pneumoniae.
Ребенку были назначены клари-тромицин из расчета 15 мг/кг/ сут, муколитики, гормональная терапия (преднизолон из расчета 1 мг/кг/сут). В связи с резким снижением уровня гемоглобина проведено переливание эритро-цитарной массы. На фоне проводимой терапии состояние ребенка стабилизировалось, пневмония разрешилась, бледность кожных покровов уменьшилась, иктерич-ность исчезла.
В контрольном клиническом анализе крови: Hb 103 г/л, эритроциты - 3,9 х 10 12 , ЦП 0,79, МС/ 72 fL, MCH 27 pg, ретикулоциты - 4%, тромбоциты 337 тыс, лейкоциты -22,9 тыс, с/я - 35%, лимфоциты -58%, моноциты 7%, СОЭ 3 мм/ч. В данном анализе, наряду с повышением уровня гемоглобина, отмечается рост количества ретикуло-цитов, лейкоцитов, тромбоцитов, что свидетельствует об активной гемопоэтической функции костного мозга и подтверждает гиперрегенераторный характер анемии. После купирования пневмонии ребенок был переведен в гематологическое отделение Измайловской ДГКБ для дообследования и уточнения характера гемолитической анемии.
Клинический пример № 3
Мальчик В., 1 год, госпитализирован в грудное инфекционное отделение Тушинской ДГБ с клиникой острой респираторной вирусной инфекции, жалобами на повышение температуры до 39 °С, насморк. Из анамнеза известно, что мальчик от женщины 30 лет, от первой беременности, протекавшей физиологически. У матери с 2004 года диагностирована желе-зодефицитная анемия (снижение гемоглобина до 90 г/л), в связи с которой она нерегулярно получала короткие курсы препаратов железа с нестойким положительным эффектом. Роды срочные, физиологические. Вес ребенка при рождении 3400 г, рост - 52 см, оценка по шкале Апгар 8/9 баллов. С рождения мальчик находился исключительно на грудном вскармливании, прикорм введен с 6 месяцев с использованием продуктов только домашнего приготовления. До 1 года ребенок не болел. Профилактические прививки не проведены в связи с отказом родителей. Аллергоанамнез не отягощен. Настоящее заболевание началось остро за 2 дня до поступления в стационар с повышения температуры до фебрильных значений, появления насморка. Стойкое повышение температуры, несмотря на проводимое симптоматическое лечение и прием жаропони-
жающих препаратов, послужило поводом для госпитализации в стационар. Данные осмотра при поступлении: состояние ребенка средней тяжести, симптомы интоксикации выражены умеренно. Кожные покровы бледные, чистые. Выражены катаральные явления. В легких хрипы не выслушиваются. Тоны сердца звучные, нежный систолический шум на верхушке. Печень и селезенка не увеличены. Физиологические отправления в норме. Показатели гемограммы: Hb 83 г/л, эритроциты - 3,4 х 10 12 , ЦП 0,73, МС/ 50 fL, MCH 24 pg, MCHC 30,25%, RDW 16,5%, ретикулоци-ты - 0,2%, тромбоциты 380 тыс, лейкоциты - 9,9 тыс, с/я - 46%, лимфоциты - 48%, моноциты 6%, СОЭ 11 мм/ч.
Результаты проведенного анализа свидетельствуют о наличии у ребенка гипохромной микроцитар-ной гипорегенераторной анемии, что в сочетании с данными анамнеза позволяет предполагать ее железодефицитный характер. В биохимическом анализе крови отмечается снижение уровня сывороточного железа 3,3 мкмоль/л, ферритина 40 нг/мл, повышение ОЖСС 65 мкмоль/л. Анализ мочи, исследование кала на скрытую кровь, ультразвуковое исследование брюшной полости патологии не выявили. Таким образом, у мальчика была диагностирована железодефицитная анемия средней степени тяжести. После купирования симптомов ОРВИ ребенок был выписан домой с рекомендацией приема препаратов железа.
Терапия анемических состояний не должна заключаться лишь в попытках нормализации уровня гемоглобина. Как видно из представленных клинических примеров, в первом и втором случаях дети нуждались в специализированном гематологическом обследовании и лечении. Несвоевременная постановка диагноза и назначение препаратов железа этим пациентам могли бы привести к прогресси-рованию основного заболевания и ухудшению прогноза для ребенка. Тем не менее, следует отметить, что гематоонкологические заболевания и гемолитические анемии в практике педиатра встречаются не очень часто, а в большинстве случаев врачу приходится сталкиваться именно с железодефицит-ными анемиями.
По данным ВОЗ, железодефицит-ные состояния занимают первое место среди 38 наиболее распространенных заболеваний человека и охватывают более 3 млрд людей на Земле. В России, по различным данным, железодефицитная анемия регистрируется у 6-40% детского населения [6, 7].
Таблица 5. Причины железодефицитной анемии у детей
Причины ЖДА
Нарушение маточно-плацентарного кровообращения, плацентарная недостаточность (токсикозы, угроза прерывания и перенашивание беременности, гипоксический синдром, острые или обострение соматических и инфекционных заболеваний)
Классификация гемолитических анемий - этиологическая, патогенетическая
Классификация гемолитических анемий - этиологическая, патогенетическая
Этиопатогенетическая классификация гемолитических анемий. Процесс патологического внутрисосудистого или внутриклеточного расплавления крови результат врожденного нарушения проницаемости оболочки или действия средовых факторов. В одинаковой мере этот процесс возникает при врожденных сдвигах или под влиянием приобретенных факторов, определяющих аномалии внутренних структур, гемоглобина или метаболическоферментативного набора.
В зависимости от интенсивности действия факторов проницаемости, за счет оболочечных и эндоэритроцитных поражений, происходит внутрисосудистое расплавление крови, в условиях выделения гемоглобина в кровообращение или изменения пластичности, а внутриклеточное — с пожиранием жестких эритроцитов.
С учетом общих механизмов гемолитических процессов, сокращающих продолжительность жизни красных кровяных клеток, классификацию гемолитических анемий можно провести по вызывающим их этнологическим факторам, которые, своим специфическим действием изменения физических постоянных или биохимических структур гематий определяют характерные патогенетические механизмы.
Давно признанная и наиболее обширная классификация, которая, с небольшими изменениями, приводится в современных трудах, делит гемолитические анемии на следующие две крупные группы:
а) эндоэритроцитные, при которых структурные изменения имеют врожденный характер и обусловливают раннее расплавление крови, за счет сокращения продолжительности жизни;
б) экзоэритроцитные, при которых нарушение нормальной структуры происходит под воздействием внешних факторов внутренней или даже наружной среды.
В первой врожденной группе отличаются генетические недостатки строения оболочки, гемоглобина, набора ферментов и реже гема гемоглобина.
Так, различаются, анемии за счет недостатка сболочки — для которых типична гемолитическая микросфероцитная анемия; анемия, развивающаяся при болезнях гемоглсбина; энзимопатическая анемия.
Экзоэритроцитные анемии составляют весьма разнородную группу, их классификация делается с учетом группы гемолитических факторов, изменяющих строение оболочки, гемоглобина или метаболических структур. С этиологической точки зрения различаются экзоэритроцитная гемолитическая анемия за счет физических, химических, медикаментозных, промышленных, токсически инфекционных факторов, растительных или животных ядов и часто встречаемая гемолитическая анемия, обусловливаемая иммунологическим механизмом.
Из предложенных в отдельных работах классификаций считаем наиболее полной разработанную Wintrobe, которую, с небольшими изменениями приводим ниже.
Классификация гемолитических анемий (по Wintrobe)
I.Внутрительцевые недостатки как причина гемолитических анемий
A. Наследственный сфероцитоз.
Б. Наследственный эллиптоцитоз (овалоцитоз).
B. Наследственные гемолитические расстройства за счет ферментативной и метаболической неполноценности, в том числе:
1. недостаточность глюкозо-6-фосфатдегидрогеназы;
2. иные виды недостаточности в процессе анаэробного метаболизма.
Д. Наследственная гемоглобинопатия:
1. гемолитическая болезнь с серповидными эритроцитами (серпоклеточная анемия);
2. расстройства гемоглобина С;
3. прочие виды гемоглобинопатии.
Е. Сочетание талассемии и гемолитической болезни с серповидными эритроцитами или прочими видами гемоглобинопатии.
Ж. Наследственная анемия с тельцами Гейнца и заболевания, обусловливаемые «неустойчивыми » гемоглобинами:
1. анемия с тельцами Гейнца;
2. гемоглобинопатии Ube-I;
3. гемоглобинопатия Цюрих;
4. прочие заболевания за счет неустойчивых гемоглобинов.
З. Ночная пароксизмальная гемоглобинурия.
И. Эритропоэтическая порфирия.
II. Внетельцееые причины гемолитических анемий
А. Возбудители инфекции:
1. протозойные паразиты (малярия, токсоплазмоз);
2. иепротозойные паразиты крови (Bartonella);
3. вирусы (первичная атипичная пневмония, инфекционный мононуклеоз); 4. бактерии (Cl. Welchii).
Б. Химические факторы:
а) в зависимости от величины дозы: фенилгидразин, свинец, анилин, тринитротолуол, метилхлорид, фенацетин, толуол, алилпропилдисульфид, ацетанилид, бензол, альфа-метилдопа, промин, нитробензол, мышьяк, коллоидальное серебро, динитробензол, сапонин, лецитин
б) в зависимости от чувствительности: сульфонамиды, сульфоны, мотилгидантоин, примахин, стибофен (фуадии), пробенецид, памахин, нитрофурантоин, бензедрин, хинин, фенотиазин, неоарсфенамин, хинидин, феназопиридин, пенициллин, нафталин, фенилсемикарбазид, стрептомицин, заместители витамина К, парафенилиндиамин мианезин, парааминосалициловая кислота,
В. Физические факторы:
1. ожоги
2. вальвулярный протез
3. сосудистые болезни (гемолитическая микроангиопатическая анемия)
4. гипероксия
5. ионизирующие излучения
Г. Растительный (фасоля Vicia fava) и житовный (змеиный яд, отдельные пауки) яды
Д. Выявимые антитела :
1. Изоантитела:
а) реакция на переливание (анти-А, анти-В, анти-резус, анти-Келл и пр.);
б) гемолитическая болезнь новорожденного.
2. Аутоантитела:
а) холодовая пароксизмальная гемоглобинурия, за счет холодовых агглютининов или гемолиза.
б) симптоматические гемолитические анемии:
(1) расстройство кроветворения:
— лимфатическая хроническая анемия
— болезнь Годжкина
— лимфосаркома
— прочие расстройства (саркоидоз и пр.)
(2) коллагеноз (в основном рассенная красная волчанка)
в) приобретенная генуинная гемолитическая анемия, за счет тепловых или холодовых антител.
Е. Неизвестные механизмы:
1. сочетающиеся со спленомегалией (миелофиброз, конгестивная спленомегалия, тромбоз селезеночной вены и пр.)
2. сочетающиеся со злокачественными опухолями (яичинков и пр.)
3. сочетающиеся с заболеваниями различного вида (уремией, болезнями печени)
4. тромботическая тромбоцитопеническая пурпура.
Редактор: Искандер Милевски. Дата обновления публикации: 18.3.2021
Информация на сайте подлежит консультации лечащим врачом и не заменяет очной консультации с ним.
См. подробнее в пользовательском соглашении.
138. Гемолитические анемии: классификация, патогенез, картина крови.
Гемолитическая анемия — анемия, возникающая, когда разрушение эритроцитов преобладает над их образованием.
Классификация. По этиологии гемолитические анемии подразделяются на приобретенные и наследственные. В свою очередь в зависимости от этиологических факторов, вызвавших гемолиз эритроцитов, приобретенные гемолитические анемии делятся на токсические, обусловленные действием экзогенных и эндогенных гемолитических ядов; иммунные (гетеро-, изо-, аутоиммунные), когда гемолиз происходит под влиянием комплекса антиген — антиэритроцитарное антитело; механические— при механическом повреждении эритроцитов; мембранопатии, связанные с соматической мутацией пролиферирующих клеток эритроцитарного ряда и образованием популяции эритроцитов с дефектом структуры мембраны.
На основании того, какие генетические нарушения привели к усилению гемолиза эритроцитов, наследственные гемолитические анемии подразделяют на наследственные мембранопатии, ферментопатии и гемоглобинопатии, вызванные генетическими дефектами структуры мембраны, активности ферментов эритроцитов и синтеза гемоглобина. Имеется две разновидности наследственных гемоглобинопатий: анемии, связанные с нарушением синтеза цепей глобина, и анемии, обусловленные наследственным дефектом первичной структуры цепей глобина.
Этиология приобретенных гемолитических анемий. Токсическая гемолитическая анемия может развиться под влиянием гемолитических ядов (соединения мышьяка, свинца, нитробензол, фенилгидразин; алкоголь, желчные кислоты, токсические продукты азотистого обмена; змеиный, грибной, пчелиный яды и др.), а также при действии возбудителей инфекционных и паразитарных заболеваний (гемолитический стрептококк, анаэробная инфекция, малярийный плазмодий, лейшмания).
Иммунная (гетеро-, изо-, аутоиммунная) гемолитическая анемия развивается при переливании несовместимой крови; резус-несовместимости матери и плода; образовании аутоантител против собственных эритроцитов при изменении их антигенных свойств под влиянием лекарственных препаратов, вирусов, МО или в результате соматической мутации иммуноцитов, когда возникает "запретный" клон лимфоцитов, продуцирующих антитела к нормальным антигенам эритроцитов (при лейкозе, системной красной волчанке и др.).
Механическое повреждение эритроцитов может возникнуть при протезировании кровеносных сосудов и клапанов сердца, длительном марше или беге по твердому грунту (маршевая гемоглобинурия), спленомегалии.
Причиной приобретенной мембранопатии может стать соматическая мутация эритробластов под действием вирусов, МО, лекарственных препаратов с образованием
патологической популяции эритроцитов, у которых нарушается структура мембраны и повышается чувствительность к комплементу (паро- ксизмальная ночная гемоглобинурия).
Патогенез. Механизм гемолиза при приобретенной гемолитической анемии заключается в повреждении структуры мембран эритроцитов. Одни гемолитические факторы (например, механические) оказывают прямое повреждающее действие, другие (мышьяковистый водород, нитриты), являясь сильными окислителями, вызывают сначала метаболические, а затем функциональные и структурные изменения в мембране и строме эритроцитов, приводящие к их гемолизу. Многие гемолитические яды биологического происхождения обладают ферментной активностью (лецитиназная активность стрепто-, стафилолизинов, яда насекомых и змей), разрушая лецитин мембран. При иммунных гемолитических анемиях IgG и IgM присоединяют к эритроцитарной мембране комплемент, который при этом активируется и вызывает ее ферментативный лизис.
Под влиянием гемолитических агентов в мембранах эритроцитов образуются поры, через которые из клетки выходят ионы калия, фосфаты, а ионы натрия поступают в клетку. Вследствие сдвигов ионного баланса вода проникает в эритроцит, который при этом набухает, приобретает сферическую форму, его клеточная поверхность уменьшается, снижается способность к деформации. Такие сфероциты не могут пройти через межэндотелиальные поры синусов селезенки и фагоцитируются селезеночными макрофагоцитами. Когда объем эритроцита достигает критического (146 % первоначального), а размер пор мембраны превышает 6 нм, наступает гемолиз с выходом гемоглобина в плазму.
Гемолиз эритроцитов при приобретенных гемолитических анемиях происходит преимущественно в кровеносном русле. Однако при резус- конфликте (гемолитическая болезнь новорожденных) антирезусные агглютинины, образовавшиеся в организме резус-отрицательной матери, вызывают гемолиз резус-положительных эритроцитов плода или новорожденного не только внутри сосудов, но и в печени и селезенке (внутриклеточный гемолиз).
При наследственной гемолитической анемии гемолиз обусловлен снижением осмотической и механической резистентности эритроцитов с генетически детерминированными нарушениями структуры мембраны, метаболизма, синтеза гемоглобина.
Так, при наследственной мембранопатии (микросфероцитарная гемолитическая анемия или болезнь Минковского—Шоффара с аутосомно-доминантным наследованием) генетический дефицит в мембране эритроцитов Са п -зависимой АТФазы и фосфолипидов приводит к повышению проницаемости мембраны. В клетки поступают ионы натрия и вода, эритроциты превращаются в сфероциты с резко пониженной способностью деформироваться при прохождении через синусы селезенки. Отрыв части оболочки у таких эритроцитов ведет к образованию микросфероцитов с укороченной продолжительностью жизни (8 — 14 дней вместо 120 дней в норме) в связи с захватом их макрофагоцитами селезенки и печени (внутриклеточный гемолиз).
При наследственной ферментопатии, например глюкозо-6- фосфатдегидрогеназодефицитной анемии (доминантное, сцепленное с X- хромосомой наследование), острый внутрисосудистый гемолиз эритроцитов, возникающий при приеме лекарств с высокой окислительной способностью (противомалярийные препараты, фтивазид и др.), обусловлен повреждением клеточных мембран перекисями, так как в эритроцитах с дефицитом Г-6-ФДГ понижено содержание восстановленного глутатиона (антиоксиданта).
Внутриклеточный гемолиз эритроцитов при наследственной гемоглобинопатии связан с синтезом аномального или не свойственного данному возрасту гемоглобина. Так, при серповидно- клеточной анемии образуется HbS (в (3-цепи глобина глутаминовая кислота заменена валином), который в восстановленном состоянии выпадает в кристаллы и вызывает деформацию эритроцитов (серповидная форма); гипоксия способствует усилению гемолиза таких эритроцитов. Следствием массивного гемолиза эритроцитов является анемия с нарушением дыхательной функции крови и развитием гипоксии. Образовавшийся при распаде эритроцитов гемоглобин циркулирует в крови (гемоглобинемия) и соединяется с гаптоглобином в крупномолекулярный комплекс, не проходящий через почечный фильтр. Если же содержание свободного гемоглобина в плазме превышает 20,9 ммоль/л (337 г/л) или исходный уровень гаптоглобина низкий, тогда не связанный с последним гемоглобин начинает выделяться с мочой (гемоглобинурия). Частично гемоглобин поглощается клетками макрофагоцитарной системы и расщепляется в них до гемосидерина. Гемосидероз селезенки, почек, печени, костного мозга сопровождается реактивным разрастанием соединительной ткани и нарушением функций этих органов. Повышенное образование из гемоглобина желчных пигментов обусловливает развитие гемолитической желтухи. Кроме того, внутрисосудистый распад эритроцитов может привести к появлению тромбов и нарушению кровоснабжения тканей, отсюда — трофические язвы конечностей, дистрофические изменения в селезенке, печени, почках. В результате поступления в сосудистое русло большого количества эритроцитарного тромбопластина возможно развитие ДВС-синдрома.
Картина крови. Приобретенная гемолитическая анемия по типу кроветворения является эритробластической, по степени регенерации костного мозга — регенераторной, по цветовому показателю — нормо- или гипохромной, реже — ложногиперхромной (вследствие абсорбции гемоглобина на эритроцитах). Степень уменьшения количества эритроцитов и гемоглобина зависит от интенсивности гемолиза. В мазке крови обнаруживаются клетки физиологической регенерации и дегенеративно измененные эритроциты (пойкилоцитоз; разорванные, фрагментированные эритроциты, анизоцитоз). Появление большого количества эритробластов и нормобластов характерно для гемолитической болезни новорожденных.
При наследственной гемолитической анемии отмечается усиленная регенерация эритроцитарного ростка часто с неэффективным эритропоэзом, когда в костнбм мозге разрушаются ядерные формы эритроцитов. В мазке крови наряду с регенеративными формами (высокий ретикулоцитоз, полихроматофилия, единичные ядерные формы эритроцитов) находятся дегенеративно измененные клетки (микросферо- циты при болезни Минковского — Шоффара, серповидные при S- гемоглобинопатии, мишеневидные, базофильно пунктированные — при талассемии). При частых гемолитических кризах может возникнуть гипорегенераторная анемия.
Аутоиммунная гемолитическая анемия
Аутоиммунная гемолитическая анемия обусловлена аутоантителами, которые реагируют с эритроцитами при температуре ≥ 37 ° С (гемолитическая анемия с тепловыми антителами) или < 37 ° С (болезнь холодовых антител). Тип гемолиза обычно внесосудистый. Прямой антиглобулиновый тест (прямая проба Кумбса) позволяет установить диагноз и предположить причину. Лечение зависит от причины и может включать применение кортикостероидов, внутривенных иммуноглобулинов, иммуносупрессантов, спленэктомию, также требуются отказ от гемотрансфузий (за исключением случаев опасной для жизни анемии), избегания триггеров (например, простуды) и отмены препаратов.
Этиология аутоиммунной гемолитической анемии
Аутоиммунная гемолитическая анемия вызвана патологиями, которые не относятся к эритроцитам Нарушений, не относящихся к эритроцитам По окончании срока нормальной продолжительности жизни (около 120 дней) эритроциты удаляются из кровотока. Гемолиз определяется как преждевременная деструкция и, следовательно, укорочение продолжительности. Прочитайте дополнительные сведения .
Гемолитическая анемия, обусловленная тепловыми антителами
Гемолитическая анемия с тепловыми антителами является наиболее распространенной формой аутоиммунной гемолитической анемии (АИГА); она чаще встречается среди женщин. Тепловые антитела, как правило, вступают в реакцию при температуре ≥ 37 ° С. Аутоиммунную гемолитичемкую анемию можно классифицировать как:
Вторичные (возникают в связи с основным заболеванием, таким как системная красная волчанка (СКВ) Системная красная волчанка (СКВ) Системная красная волчанка – хроническое мультисистемное воспалительное заболевание аутоиммунной природы; поражает преимущественно молодых женщин. Наиболее часто заболевание проявляется артралгиями. Прочитайте дополнительные сведенияНекоторые препараты (например, альфа-метилдопа, леводопа—см. таблицу Лекарственные средства, которые вызывают гемолитическую анемию тепловых агглютининов Лекарственные средства, которые вызывают гемолитическую анемию тепловых агглютининов ) стимулируют продукцию аутоантител к Rh-антигенам (аутоиммунная гемолитическая анемия, ассоциированная с применением альфа-метилдопы). Другие препараты стимулируют продукцию аутоантител к мембранному комплексу антибиотик – эритроцит как часть транзиторного гаптенового механизма; гаптен может быть стабильным (высокие дозы пенициллина, цефалоспорины) или нестабильным (хинидин, сульфаниламиды).
При гемолитической анемии тепловых агглютининов, гемолиз происходит в основном в селезенке и не связан с непосредственным лизисом эритроцитов. Он часто достигает тяжелой степени и может приводить к летальному исходу. Большая часть тепловых аутоантител относится к IgG. Они являются панагглютининами и чаще всего характеризуются ограниченной специфичностью.
Болезнь холодовых агглютининов
Болезнь холодовых агглютининов (болезнь холодовых антител) вызывают аутоантитела, которые активны при температурах < 37 ° С. Причины включают:
Идиопатические (как правило, связаны с клональной популяцией В-клеток)
Инфекции, особенно микоплазменная пневмония или инфекционный мононуклеоз (антитела направлены против I или I антигенов)
Лимфопролиферативные нарушения (антитела, как правило, направлены против антигена I)
Инфекции, как правило, вызывают острое заболевание, в то время как идиопатическое заболевание (распространенная форма у пожилых людей), зачастую, носит хронический характер. Наблюдается преимущественно внесосудистый гемолиз, который осуществляется мононуклеарной фагоцитарной системой печени и селезенки. Анемия, как правило, не достигает тяжелой степени (гемаглобин > 7,5 г/дл [70,5 г/л]). Холодовые аутоагглютинины обычно относятся к IgM. Температурная амплитуда антител более важна, чем их титр; повышение температуры (приближение к нормальной температуре тела), при которой данные антитела реагируют с эритроцитами, усиливает гемолиз.
Пароксизмальная холодовая гемоглобинурия
Пароксизмальная холодовая гемоглобинурия (ПХГ, синдром Доната – Ландштейнера) относится к редкому типу болезни холодовых агглютининов. ПХГ чаще встречается у детей. Гемолиз возникает при воздействии холода, даже локальном (употребление холодных напитков, мытье рук в холодной воде). При низкой температуре антитело IgG связывается с Р-антигеном на поверхности эритроцитов и вызывает внутрисосудистый гемолиз и гемоглобинурию при последующем нагревании. Данное заболевание чаще всего развивается после перенесенной неспецифической вирусной инфекции, однако может возникать и на фоне полного здоровья, а также у некоторых пациентов с врожденным или приобретенным сифилисом Сифилис Сифилис вызывается спирохетой Treponema pallidum и характеризуется 3 последовательными клиническими, симптоматическими стадиями, отделенными периодами бессимптомной скрытой инфекции. Прочитайте дополнительные сведения . Тяжесть анемии и скорость ее развития варьирует, может наблюдаться фульминантное течение. У детей это заболевание часто разрешается самостоятельно.
Симптомы и признаки аутоиммунной гемолитической анемии
Симптомы гемолитической анемии с тепловыми антителами обусловлены анемией. При тяжелом течении могут наблюдаться лихорадка, боль в груди, обмороки, печеночная или сердечная недостаточность. Характерна легкая спленомегалия.
Болезнь холодовых агглютининов манифестирует как острая или хроническая гемолитическая анемия. Могут присутствовать другие криопатические симптомы или признаки (например, акроцианоз, синдром Рейно Синдром Рейно Синдром Рейно – спазм сосудов кистей в ответ на воздействие холода или эмоционального напряжения, вызывающий обратимый дискомфорт и изменение цвета кожи (бледность, цианоз, эритема или их комбинация). Прочитайте дополнительные сведенияМожет присутствовать гепатоспленомегалия. К симптомам ПХГ относятся следующие проявления: сильная боль в спине и ногах, головная боль, рвота, диарея, выделение мочи темно-коричневого цвета.
Диагностика аутоиммунной гемолитической анемии
Мазок периферической крови, количество ретикулоцитов, лактатдегидрогеназа (ЛДГ)
Прямой антиглобулиновый тест
Аутоиммунную гемолитическую анемию следует подозревать у любого пациента с гемолитической анемией (о чем может свидетельствовать наличие анемии и ретикулоцитоза). В мазке периферической крови обычно выявляются микросфероциты и большое количество ретикулоцитов с небольшим количеством или отсутствием шистоцитов, что указывает на внесосудистый гемолиз. Лабораторные исследования обычно указывают на гемолиз (например, повышение ЛДГ и непрямого билирубина). Высокий показатель среднего объема эритроцитов (MCV) может быть следствием сильного ретикулоцитоза. Гемолитическая анемия при низком количестве ретикулоцитов встречается редко, но может возникать и является признаком тяжелого заболевания.
Аутоиммунная гемолитическая анемия диагностируется путем выявления аутоантител с помощью прямого антиглобулинового теста (прямой реакции Кумбса). Антиглобулиновую сыворотку добавляют к отмытым эритроцитам пациента; агглютинация свидетельствует о наличии иммуноглобулинов или комплемента (С), связанного с эритроцитами. При гемолитической анемии с синдромом тепловых агглютининов IgG присутствует почти всегда, а также могут присутствовать C3 (C3b и C3d). При болезни холодовых антител присутствует С3, а IgG обычно отсутствует. Данный тест в отношении диагностики аутоиммунной гемолитической анемии имеет чувствительность ≥ 98%; ложноотрицательные результаты могут наблюдаться в том случае, если плотность антител крайне низкая либо, достаточно редко, если они относятся к классу IgA или IgM. В большинстве случаев аутоиммунной гемолитической анемии с тепловыми антителами антитело представляет собой IgG, который идентифицируют только как панагглютинин, это означает, что антигенную специфичность антитела определить не возможно. При болезни холодовых агглютининов антитело, как правило, является IgM и направлено против углеводов I/i на поверхности эритроцитов. Обычно можно определить титр антител, но он не всегда коррелирует со степенью активности заболевания. Прямой антиглобулиновый тест (прямая проба Кумбса) может быть положительным при отсутствии аутоиммунной гемолитической анемии, поэтому его следует проводить только в надлежащих клинических условиях. Ложноположительный прямой антиглобулиновый тест может быть результатом присутствия клинически незначимых антител.
Непрямой антиглобулиновый тест (непрямая проба Кумбса) является дополнительным тестом, который заключается в смешивании плазмы пациента с нормальными эритроцитами, чтобы определить, находятся ли такие антитела в свободном состоянии в плазме. Как правило, положительный непрямой антиглобулиновый тест в сочетании с отрицательным прямым тестом означает наличие аллоантител, обусловленных беременностью, предшествующими гемотрансфузиями, перекрестной лектиновой активностью, а не иммунным гемолизом. Необходимо учитывать, что даже обнаружение тепловых антител не свидетельствует о наличии гемолиза, поскольку положительная проба Кумбса наблюдается у 1/10000 здоровых доноров крови.
Прямой антиглобулиновый тест (прямая проба Кумбса)
Прямая проба Кумбса применяется для определения эритроцит-связывающих антител (IgG) или наличия комплемента (С3) на мембранах эритроцитов. Эритроциты больного инкубируют с антителами к человеческим иммуноглобулинам IgG и С3. Если антитела класса IgG или С3 связываются с мембраной эритроцитов, происходит агглютинация - положительный результат Положительный результат предполагает наличие аутоантител к эритроцитам, если пациент не получал переливание крови в течение последних 3 мес, аллоантитела к перелитым эритроцитам (обычно наблюдается при острой или отсроченной гемолитической реакции) или лекарственно-зависимые антиэритроцитарные антитела.
Анемия: классификация, профилактика, лечение. Справка

Патологическое состояние, которое характеризуется снижением уровня гемоглобина в крови и может сопровождаться снижением количественного содержания эритроцитов в единице объема, называется анемией.
Анемией называется патологическое состояние, которое характеризуется снижением уровня гемоглобина в крови и может сопровождаться снижением количественного содержания эритроцитов в единице объема.
В клинической практике наиболее распространена следующая классификация анемий:
– анемии, обусловленные острой кровопотерей;
– анемии вследствие нарушения продукции эритроцитов: апластические, железодефицитные, мегалобластные, сидеробластные, хронических заболеваний;
– анемии вследствие повышенного разрушения эритроцитов: гемолитические.
В зависимости от выраженности снижения уровня гемоглобина выделяют три степени тяжести анемии: легкая – уровень гемоглобина выше 90 г/л; средняя – гемоглобин в пределах 90‑70 г/л; тяжелая – уровень гемоглобина менее 70 г/л.
Различные виды анемий выявляются у 10‑20% населения, в большинстве случаев у женщин. Наиболее часто встречаются анемии, связанные с дефицитом железа (около 90% всех анемий), реже анемии при хронических заболеваниях, еще реже анемии, связанные с дефицитом витамина В12 или фолиевой кислоты (мегалобластные), гемолитические и апластические.
Анемия может иметь сложное происхождение. Возможно сочетание железодефицитной и В12‑дефицитной анемий.
Общие симптомы анемий:
– слабость, повышенная утомляемость, снижение работоспособности, раздражительность, сонливость;
– головокружение, головные боли, шум в ушах, мелькание "мушек" перед глазами;
– сердцебиение при небольшой физической нагрузке или в покое;
– одышка при небольшой физической нагрузке или в покое.
Характер и выраженность жалоб при анемии разнообразны и зависят от вида, степени тяжести анемии, скорости ее развития и индивидуальных особенностей больного.
Принципы профилактики и лечения зависят от вида анемии.
Железодефицитная анемия (ЖДА) – клинико‑гематологический синдром, характеризующийся дефицитом железа вследствие различных патологических (физиологических) процессов.
ЖДА проявляется астеническими симптомами (утомляемость, значительно сниженная работоспособность, ухудшение внимания и памяти), мышечной слабостью и синдромом эпителиопатии (сухость кожи, "заеды" в углах рта, ломкость и слоистость ногтей, выпадение волос и др.). Поражение слизистых у больных ЖДА проявляются такими симптомами, как затруднения глотания (сидеропеническая дисфагия), дизурические расстройства (нарушение актов мочеиспускания), развитие атрофических пангастритов с секреторной недостаточностью, нарушение белковосинтетической, энергосберегающей и ферментной функций печени.
По мере развития и усугубления ЖДА развиваются нарушения со стороны сердечно-сосудистой системы в виде миокардиодистрофии, диастолической дисфункции с нарушением пассивного расслабления, гиперкинетического типа кровообращения.
Основные причины ЖДА включают:
– хронические кровопотери: десневые, носовые, желудочные, кишечные, маточные, почечные;
– нарушение всасывания: энтериты, резекция кишечника, операция резекции желудка;
Читайте также:
